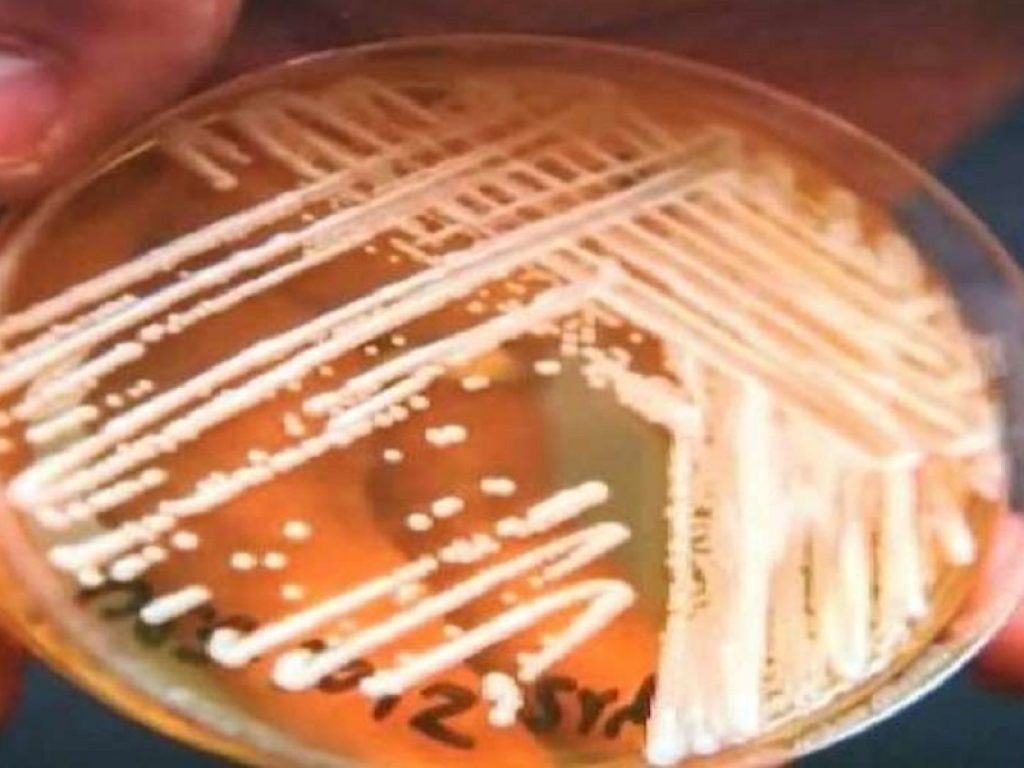
La Candida auris resiste ai farmaci e al caldo: con il surriscaldamento del pianeta gli esperti lanciano l'allarme per nuove infezioni

La Candida auris resiste ai farmaci e al caldo: con il surriscaldamento del pianeta gli esperti lanciano l’allarme per nuove infezioni
Potrebbero essere i cambiamenti climatici ad aver facilitato la diffusione di un fungo altamente patogeno e resistente ai farmaci, la Candida auris, su cui oggi, ultimo in ordine di tempo, è stato il Canada a lanciare un allarme. A studiare il comportamento del fungo sono stati gli esperti guidati da Arturo Casadevall alla Johns Hopkins Bloomberg School of Public Health di Baltimora (Usa), che hanno pubblicato una ricerca sulla rivista ‘mBio’.
La Candida auris, praticamente sconosciuta fino al 2009, negli ultimi 10 anni ha fatto registrare diversi focolai di infezione negli ospedali e nelle strutture di lungodegenza in tutto il mondo, principalmente tra i pazienti con sistema immunitario indebolito, come le persone sottoposte a chemioterapia o chirurgia, ma anche fra coloro che ricevono altri tipi di farmaci per via endovenosa.
In Canada si sono registrati 20 casi di Candida auris dal 2012 a giugno 2019, ha reso noto la Public Health Agency of Canada. “Finora la C. auris era rimasta relativamente rara”, ha affermato Isaac Bogoch, medico di malattie infettive al Toronto General Hospital. Ma questo fungo, che può causare infezioni del sangue, delle ferite e delle orecchie, ha tre caratteristiche principali che lo rendono particolarmente preoccupante: è difficile da identificare, è difficile da trattare con successo quando invade il flusso sanguigno ed è spesso resistente a una o più classi di farmaci antimicotici a cui i medici si rivolgono per primi”.